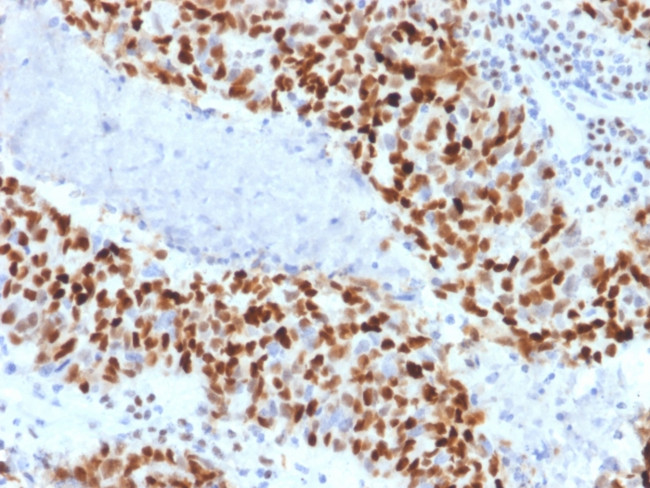
Cyclin E (G1/S-Phase Cyclin) Antibody in Immunohistochemistry (Paraffin) (IHC (P))

Search
NeoBiotechnologies
Cyclin E (G1/S-Phase Cyclin) Monoclonal Antibody (CCNE1/2460)
{{$productOrderCtrl.translations['antibody.pdp.commerceCard.promotion.promotions']}}
{{$productOrderCtrl.translations['antibody.pdp.commerceCard.promotion.viewpromo']}}
{{$productOrderCtrl.translations['antibody.pdp.commerceCard.promotion.promocode']}}: {{promo.promoCode}} {{promo.promoTitle}} {{promo.promoDescription}}. {{$productOrderCtrl.translations['antibody.pdp.commerceCard.promotion.learnmore']}}
产品信息
898-MSM1-P1ABX
种属反应
宿主/亚型
分类
类型
克隆号
抗原
偶联物
形式
浓度
规格
纯化类型
保存液
内含物
保存条件
运输条件
靶标信息
Cyclin E belongs to the highly conserved cyclin family, whose members are characterized by a dramatic periodicity in protein abundance through the cell cycle. Cyclins function as regulators of CDK kinases. Different cyclins exhibit distinct expression and degradation patterns which contribute to the temporal coordination of each mitotic event. Cyclin E forms a complex with and functions as a regulatory subunit of CDK2, whose activity is required for cell cycle G1/S transition. This protein accumulates at the G1-S phase boundary and is degraded as cells progress through S phase. Overexpression of this gene has been observed in many tumors, which results in chromosome instability, and thus may contribute to tumorigenesis. This protein was found to associate with, and be involved in, the phosphorylation of NPAT protein (nuclear protein mapped to the ATM locus), which participates in cell-cycle regulated histone gene expression and plays a critical role in promoting cell-cycle progression in the absence of pRB. Two alternatively spliced transcript variants of this gene, which encode distinct isoforms, have been described. Two additional splice variants were reported but detailed nucleotide sequence information is not yet available.
仅用于科研。不用于诊断过程。未经明确授权不得转售。
篇参考文献 (0)
生物信息学
蛋白别名: cyclin Es; cyclin Et; E-S; G1/S-specific cyclin-E1; unnamed protein product
基因别名: CCNE; CCNE1; pCCNE1
UniProt ID: (Human) P24864
Entrez Gene ID: (Human) 898